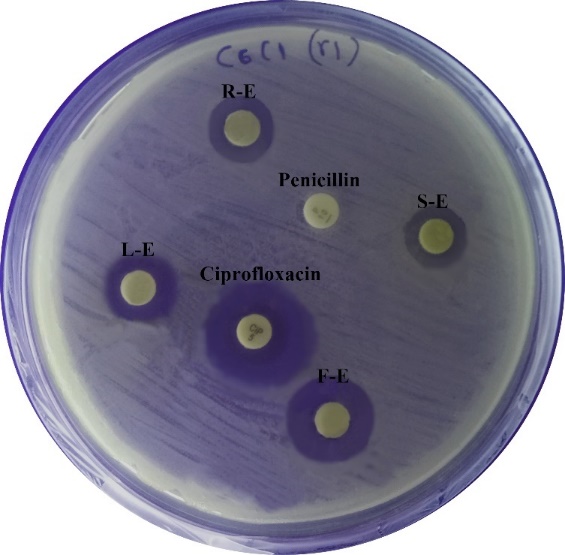
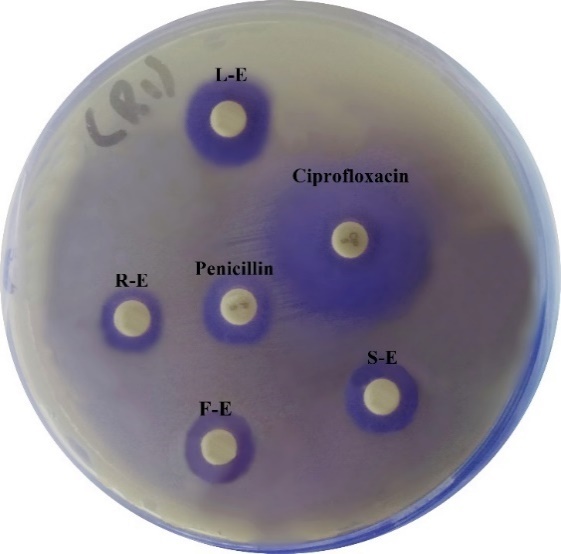
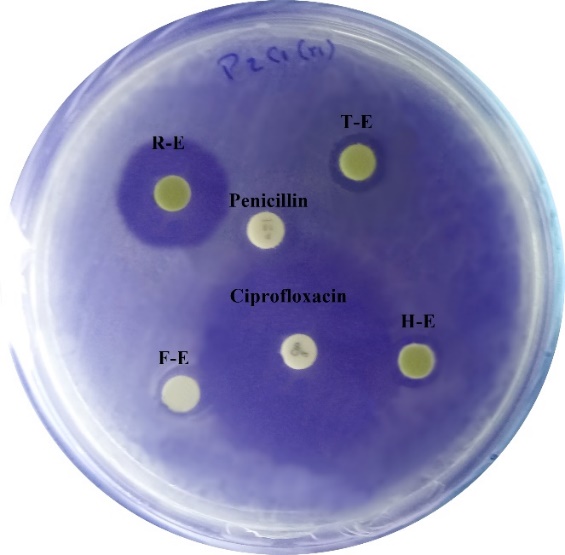

Centro de Investigación y Desarrollo Biotecnologico, Facultad de Ciencias Agropecuarias, Universidad Estatal de Bolivar, CP: 020150, Guaranda Ecuador
Email: fbayas@ueb.edu.ec
Received: 22 Nov 2019, Revised and Accepted: 21 Jan 2020
ABSTRACT
Objective: The increase in chronic and degenerative diseases and the use of synthetic antioxidants such as (butylated hydroxyanisole (BHA) or butylated hydroxytoluene (BHT)) are being restricted because they can be considered carcinogenic. Therefore, there is a growing interest in the search for natural antioxidants, especially from plants, due to their content in different bioactive compounds, such as antioxidants and antimicrobials.
To evaluate the antibacterial and antioxidant activity of Baccharislatifolia extracts.
Methods: For the determination of the antimicrobial activity of extracts of leaves, root, stem and flowers of Baccharislatifolia (Bl), the disk plate diffusion method was used, the strains of Listeria, Salmonella and E. coli were studied; antibiotics Penicillin G and Ciprofloxacin were the controls. For the antioxidant activity, a solution of H2O2 (Abs at 230 nm) was prepared in Potassium Phosphate Monobasic-Sodium Hydroxide buffer.
Results: The antimicrobial activity against Listeria and Salmonella, showed that the extracts of leaves and flowers were more effective with inhibition zones>15 mm and>20 mm respectively. In front of E. coli, the extracts of flowers and stem were the best with zones>7.0 mm. Antibiotics studied inhibited the development of Listeria and Salmonella. However, E. coli isolates were resistant. In the antioxidant activity, the flower extract of Bl in 60 mg/ml presents a higher effect with 47.25%.
Conclusion: Bl extracts from leaves and flowers were more efficient both in their antimicrobial and antioxidant capacity.
Keywords: Baccharislatifolia, Natural extracts, Antimicrobial, Antioxidant
© 2020 The Authors. Published by Innovare Academic Sciences Pvt Ltd. This is an open-access article under the CC BY license (http://creativecommons.org/licenses/by/4.0/)
DOI: http://dx.doi.org/10.22159/ijcpr.2020v12i2.37495. Journal homepage: https://innovareacademics.in/journals/index.php/ijcpr
The continuous increase of microorganisms resistant to different antimicrobial agents has been a major problem for health and food safety, it is also known that with the appearance of antibiotics the lives of millions of human beings have been saved, however, is approaching a reality of dimensions not yet considered.
Among the most used antibiotics, are the antibiotics from the group of Fluoroquinolones [1]. On the other hand, Penicillin G, according to Flores et al. [2], is an antibiotic belonging to the group of Beta-lactams, they have a mechanism of action inhibiting the cell wall of the bacteria, especially Gram+such as Listeria, Salmonella, E. coli [3-5].
The world could be in a serious phase caused by multiple lethal bacteria resistant to antibiotics, this due as the lack of innovation and development of new antibiotics, especially of a natural origin [6]. The antibiotics derived especially from vegetables (medicinal plants), have been proven to be less toxic than synthetic agents [7].
The use of extraction techniques to obtain substances with bioactive principles is of great importance at the time of obtaining the component, even, when orthodox medicines are available, a large percentage of the population still uses herbal remedies together with conventional medicines [8, 9].
These compounds are obtained by contact with solvents through extraction techniques like maceration. The effectiveness of extraction generally depends on the polarity and nature of the solvent used [10].
Antioxidant activity of plants
Oxidative damage caused by free radicals is related to the development of various diseases such as atherosclerosis, cancer, arthritis and other inflammatory diseases [11]. The existence of synthetic substances (Butylated hydroxyanisole (BHA) or Butylated hydroxytoluene (BHT)) that are efficient scavengers of free radicals; but they are being restricted because they can be considered carcinogenic [12]. So, there is a growing interest in the search for antioxidants of natural origin, especially from plants. In most cases, the antioxidant activity of these plants is mainly due to the presence of phenolic compounds, which are powerful oxygen scavengers and are also capable of inhibiting enzymes that produce free radicals [13].
The chilca (Baccharis latifolia) (fig. 1), is one of the 46 species of Baccharis genus that is widely distributed in Ecuador, in provinces such as Pichincha, Imbabura, Cañar, Cotopaxi, Chimborazo, Bolívar, Azuay, Loja, Napo, Sucumbíos and Zamora Chinchipe [14].

Fig. 1: Baccharis Latifolia plant
Baccharis latifoliait is commonly used in poultices to relieve external inflammations, fractures, dislocations and rheumatic pains; in infusions, it is used as an antidiarrheal, for asthma, menstrual pains, antidiabetic and insomnia [15]. Also, Baccharislatifolia, has been used in Latin America for medicinal purposes, such as antidiarrheal, anti-inflammatory, antidiabetic, antidepressant, analgesic and disinfectant of wounds, ulcers and antimicrobial [16].
Objective
The objective of the present study was; to determine the antimicrobial and antioxidant activity of the extracts of Baccharislatifolia.
The leaves, stems and roots of Baccharislatifolia (Bl) were collected from young plants during the months of July 2017 to July 2018 on the grounds of the Faculty of Agricultural Sciences of the Universidad Estatal de Bolívar (Ecuador). The selected plants were clean and free of damage.
Preparation of extracts
The selected leaves, stems and flowers were exposed to maceration during 6 d in 96% ethyl alcohol in a ratio 50 gr of the vegetal matter: 100 ml of alcohol, after this time, the extracts were obtained by centrifugation (Sigma, 3-16C, United Kingdom) at 10,000 rpm and filtration using of cellulose filters pore size 2.5 μm (Whatman, 1001-110, USA). The preparation of the extracts was done in duplicate and the extracts with better performance were used to Antimicrobial analysis
Collection of bacterial inocula
Baccharislatifolia Extracts (Bl-E) were tested against three bacterial genera, Escherichia coli, Salmonellaspp and Listeriaspp, these bacterial strains were provided by the Molecular Biology laboratory of the Research Department of the Universidad Estatal de Bolívar. A number of 10 isolated for each bacterial genus isolated from meats were used in the study, as control were used the type strains of the Listeriaspp, Salmonellaspp and Escherichia, the bacterial strains used are described in table 1.
Table 1: Microorganisms used in the study
| Type of meat (origin) | Sample number and selected colony | Code | Identified microorganism |
| Beef | Sample 1-Colony 2 | B1C2 | Listeria spp |
| Beef | Sample3-Colony2 | B3C2 | Listeria spp |
| Chicken | Sample3-Colony1 | C3C1 | Listeria spp |
| Chicken | Sample4-Colony2 | C4C2 | Listeria spp |
| Chicken | Sample5-Colony1 | C5C1 | Listeria spp |
| Chicken | Sample6-Colony1 | C6C1 | Listeria spp |
| Chicken | Sample8-Colony2 | C8C2 | Listeria spp |
| Chicken | Sample14-Colony3 | C14C3 | Listeria spp |
| Chicken | Sample18-Colony1 | C18C1 | Listeria spp |
| Pork | Sample19-Colony1 | P19C1 | Listeria spp |
| ATCC 33090 | Listeria innocua | ||
| Beef | Sample3-Colony2 | B3C3 | Salmonella spp. |
| Beef | Sample5-Colony1 | B5C1 | Salmonella spp. |
| Beef | Sample15-Colony3 | B15C3 | Salmonella spp. |
| Beef | Sample27-Colony1 | B27C1 | Salmonella spp. |
| Chicken | Sample2-Colony1 | C2C1 | Salmonella spp. |
| Chicken | Sample13-Colony2 | C13C2 | Salmonella spp. |
| Pork | Sample1-Colony3 | P1C3 | Salmonella spp. |
| Pork | Sample1-Colony5 | P1C5 | Salmonella spp. |
| Pork | Sample5-Colony3 | P5C3 | Salmonella spp. |
| Pork | Sample14-Colony3 | P14C3 | Salmonella spp. |
| ATCC 13314 | Salmonella arizonae | ||
| Beef | Sample2-Colony1 | B2C1 | Escherichia coli |
| Beef | Sample3-Colony1 | B3C1 | Escherichia coli |
| Beef | Sample3-Colony3 | B3C3 | Escherichia coli |
| Beef | Sample5-Colony1 | B5C1 | Escherichia coli |
| Chicken | Sample2-Colony3 | C2C3 | Escherichia coli |
| Chicken | Sample3-Colony2 | C3C2 | Escherichia coli |
| Pork | Sample2-Colony1 | P2C1 | Escherichia coli |
| Pork | Sample4-Colony1 | P4C1 | Escherichia coli |
| Pork | Sample5-Colony1 | P5C1 | Escherichia coli |
| Pork | Sample14-Colony3 | P14C3 | Escherichia coli |
| ATCC 10536 | Eschericha coli |
The microorganisms used in this study were previously identified by biochemical and molecular methods.
Antimicrobial analysis
The antibacterial activity of the four Baccharislatifolia extracts (Bl-E) of root, stem, leaves and flowers against Listeriaspp; Salmonellaspp and Escherichia coli strains were tested by the paper disc diffusion method applied by Shokeen et al. [17].
Colonies of fresh pure culture from each isolate and of the reference strains were suspended in the physiological saline solution until turbidity of 0.5 McFarland standard (equivalent to 1.5x108 UFC/m). Bacteria from each suspension were inoculated onto Muller Hilton Agar (MHA) (Neogen, 7101A, USA) using a sterile cotton-tipped swab and the plates were left standing for 10 min.
The sterile filter paper discs (Oxoid, CT0998B, United Kingdom) of 6 mm diameter were immersed in 10 ml of each extract for 7 min, then applied to the surface of the agar [18]. Sterile water was used as a negative control. The commercially available standard antibiotics, Penicilin G (Oxoid, CT0043B, UK) and Ciprofloxacin (Bioanalyse, 181129B, Turkey) were used as reference antibiotic controls. All assays were performed in duplicate. The sensitivity of microorganisms to natural extracts is related to the size of the microbial grown inhibition zone. According to the diameter of inhibition zone, microorganisms are classified in: resistant (d<8 mm), sensitive (9 mm.<d<14 mm), very sensitive (14 mm<d<19 mm) and extremely sensitive (d>20 mm) [19].
Antioxidant capacity of the Baccharislatifolia extracts
The ability of plant extracts to remove H2O2 can be estimated according to the method of Ruch et al. [20]. In this work a solution of H2O2 (40 mmol) was prepared in Potassium Phosphate Monobasic-Sodium Hydroxide buffer (50 mmol, pH 7.4) (SB108-1, Fisher Chemical, Belgium), the concentration of H2O2 was determined by absorption at 230 nm in a spectrophotometer Genesys 10 UV (Thermo Scientific 335902, USA). Subsequently, the extracts were added individually in concentrations of 20, 40 and 60 μg/ml on H2O2, the ABS was determined at 230 nm after 10 min against a blank solution containing phosphate buffer without H2O2. It should be noted that there are several methods to evaluate antioxidant capacity in vitro, although there is still no consensus on the most appropriate method, as well as, although there are markers of oxidative damage to biomolecules, the results in vivo remain contradictory [21].
The percentage of the sweep of hydrogen peroxide is calculated with the following formula:
Antioxidant capacity (% of H2O2 sequestered) = [(Ai-At)/Ai]x100.
Where: Ai= absorbance of the reference standard; At = Absorbance of the sample.
Antimicrobial activity of Bl-E against Listeria isolates
Through the inhibition analysis, it was determined that the extract of leaves and flowers presented greater effectiveness against Listeria isolates, in fact, the size of the inhibition zone presented a mean greater than 15 mm. The third extract that showed effectiveness in the analysis was root, but with smaller zone size, as shown in fig. 2. The isolates: B1C2, B3C2 and CH5C1 showed resistance to the root extract of Bl; isolates: B3C2, CH5C1 and CH14C3 resisted the stem extract; the extracts of leaves and flowers did not show effectiveness against the isolated CH5C1 and CH14C3.
Fig. 2: Antimicrobial effect of Bl-E agaists Listeria, R-E: root extract; S-E: stem extract; L-E: leave extract; F-E: flower extract
On the other hand, in the control strain (Listeria innocua, ATCC 33090) presented 23 and 22 mm in diameter of the zone in the extracts of leaves and flowers respectively, however, these two extracts did not inhibit the development of the isolate, as shown in table 2. Resistant isolates were considered to those that presented a zone size ≤8 mm in diameter [19].
Table 2: Antibacterial activity of Bl-E against strains of Listeria spp
| Antibiogram in Listeria | Inhibition diameter in mm (24 h/incubation) | ||||||
| N ° | Code | R | S | L | F | P | Cp |
| 1 | B1C2 | 8 | 12 | 12 | 18 | 21 | 24 |
| 2 | B3C2 | 4 | 4 | 12 | 18 | - | 12 |
| 3 | C3C1 | 10 | 11 | 14 | 11 | 22 | - |
| 4 | C4C2 | 12 | 14 | 20 | 21 | 18 | - |
| 5 | C5C1 | 8 | 2 | - | - | 9 | 14 |
| 6 | C6C1 | 15 | 12 | 22 | 24 | - | 24 |
| 7 | C8C2 | 24 | 18 | 20 | 15 | 22 | 20 |
| 8 | C14C3 | 10 | 8 | 2 | 2 | 21 | 14 |
| 9 | C18C1 | 20 | 24 | 16 | 9 | 4 | 27 |
| 10 | P19C1 | 12 | 11 | 20 | 18 | 18 | 18 |
| Mean | 12,3 | 11,6 | 15,3 | 15,1 | 16,9 | 19,1 | |
| Listeria innocua, ATCC 33090 | 20 | 18 | 23 | 22 | 21 | 14 | |
R = root; S = stem; L = leaves; F = flowers; Cp = ciprofloxacin; P = penicillin
Anti-listerial effect of Bl-E and antibiotics for clinical use
For penicillin G (gr), an average of 16.9 mm in diameter was obtained, not so far from the average of our best Bl extracts. It should be noted that this antimicrobial is specific to fight infections caused by Listeria, taking as reference the parameters established by CLSI2012, [22], it can be said that of the 10 isolates studied, 4 were resistant to this agent (B3C2, C5C1, C6C1 and C18C1) with zone sizes ≤14 mm.
The control strain was susceptible to the antibacterial with 21 mm diameter. On the other hand, after applying ciprofloxacin discs, 5 isolates (B3C2, C3C1, C4C2, C5C1, C14C3), showed resistance with a zone size ≤15 mm, according to the CLSI2012 [22], the control strain proved susceptible to the quinolone (table 2).
Antimicrobial activity of Bl-E against Salmonella isolates
After having measured the inhibition diameters, it was determined that all the Salmonella isolates were susceptible to the Bl extracts studied, where the extracts of leaves and flowers presented greater effectiveness, in fact, the size of the zone had a mean greater than 20 mm fig. 3.
Fig. 3: Antimicrobial effect of Bl-E against Salmonella, R-E: root extract; S-E: stem extract; L-E: leave extract; F-E: flower extract
On the other hand, in the control strain, the root of Bl extract with a zone of 22 mm acted better, followed by the leaves extract with 21 mm of inhibition zone, as shown in table 3.
Table 3: Antibacterial activity of Bl-E against strains of Salmonella spp
| Antibiogram in Salmonella | Inhibition diameter in mm (24 h/incubation) | ||||||
| N ° | Code | R | S | L | F | P | Cp |
| 1 | B5C1 | 20 | 20 | 18 | 14 | - | 28 |
| 2 | B3C3 | 26 | 28 | 22 | 18 | - | 35 |
| 3 | B15C3 | 16 | 24 | 25 | 25 | 22 | 28 |
| 4 | B27C1 | 14 | 24 | 28 | 20 | 21 | 35 |
| 5 | C2C1 | 20 | 16 | 14 | 16 | - | 31 |
| 6 | C13C2 | 23 | 16 | 22 | 16 | - | 31 |
| 7 | P1C3 | 20 | 20 | 24 | 31 | - | 35 |
| 8 | P1C5 | 20 | 20 | 18 | 26 | - | 33 |
| 9 | P5C3 | 24 | 26 | 30 | 28 | - | 31 |
| 10 | P14C3 | 22 | 16 | 20 | 14 | - | 30 |
| Mean | 20,5 | 21 | 22,1 | 20,8 | 21,5 | 31,7 | |
| Salmonella arizonaeATCC 13314 | 22 | 18 | 21 | 18 | 14 | 32 | |
R = root; S = stem; L = leaves; F = flowers; Cp = ciprofloxacina; P = penicilina
Anti-Salmonella effect of Bl extracts and antibiotics for clinical use
In the clinical antimicrobials, for penicillin G, a mean of 21 mm in diameter was obtained (in strains with inhibitory effect) value not so far from the average of the extracts of Bl, in fact, the extracts of Bl leaves acted better than this antibiotic. There were 8 strains of Salmonella that showed total resistance to Penicillin (B5C1, B3C3, C2C1, C13C2, P1C3, P1C5, P5C3, P14C3) zone size<14 mm as established by the CLSI 2012 [22], (table 2). However, it is important to consider that in the group of penicillins they are specific for Gram+microorganisms [23], so that it justifies the ineffectiveness of the antibiotic against Salmonella.
With ciprofloxacin, all isolates were shown to be susceptible to this antimicrobial agent with a zone diameter size>14 mm, according to the CLSI, 2012 [22]. The control strain was also susceptible to this quinolone.
Antimicrobial activity of Bl-E against Escherichia coli isolates
After finishing each of the zones of inhibition, it was determined that the extract of flowers and stem showed greater effectiveness against isolates of Escherichia coli with a zone size of 7.2 and 7.1 mm respectively. However, according to Ponce et al. [19], it should be considered that the microorganism is susceptible to the natural extract or oil, if the zone size is greater than 9 mm, so that the root extract alone inhibited the P2C1 strain; stem extract, the strains: B3C3 and P4C1; leaves extract, the strains: B2C1 and C3C2 and flowers extract only strain B3C3, as shown in fig. 4.
Fig. 4: Antimicrobial effect of Bl-E against Escherichia coli, R-E: root extract; S-E: stem extract; L-E: leave extract; F-E: flower extract
On the other hand, in the control strain, the root of Blextract with a zone size of 12 mm acted better, definitively all the extracts acted better than penicillin against E. coli isolates, see table 4.
Table 4: Antibacterial activity of Bl-E against strains of Escherichia coli
| Antibiogram in Escherichia coli | Inhibition diameter in mm (24 h/incubation) | ||||||
| N ° | Code | R | S | L | F | P | Cp |
| 1 | B2C1 | 8 | 4 | 10 | 8 | 6 | 30 |
| 2 | B3C1 | 4 | 6 | 8 | 8 | 4 | 15 |
| 3 | B3C3 | 2 | 14 | 4 | 20 | 8 | 26 |
| 4 | B5C1 | 4 | 6 | 8 | 4 | 4 | 24 |
| 5 | C2C3 | 4 | 8 | 4 | 6 | 6 | 22 |
| 6 | C3C2 | 4 | 4 | 10 | 6 | 4 | 30 |
| 7 | P2C1 | 20 | 8 | 6 | 4 | 6 | 38 |
| 8 | P4C1 | 8 | 9 | 4 | 8 | 4 | 16 |
| 9 | P5C1 | 4 | 8 | 4 | 4 | 4 | 24 |
| 10 | P14C3 | 8 | 4 | 8 | 4 | 2 | 22 |
| Mean | 6,6 | 7,1 | 6,6 | 7,2 | 4,8 | 24,7 | |
| Eschericha coli ATCC 10536 | 12 | 5 | 7 | 4 | 4 | 21 | |
R = root; S = stem; L = leaves; F = flowers; Cp = ciprofloxacina; P = penicilina
Anti-E. coli effect of Bl extracts and antibiotics for clinical use
For penicillin G, an average of 4,0 mm in diameter was obtained. Considering the parameters established by the CLSI 2012 [22], all the isolates showed resistance to this antibiotic, the size zone<12 mm. However, it is important to consider that in a group of penicillins they are specific for Gram+microorganisms [23], so that they justify the ineffectiveness against these isolates. After applying the ciprofloxacin discs, all the isolates sensitivity to this antibiotic, with inhibition zone sizes>13 mm.
Antioxidant capacity of Bl extracts
After this analysis it was possible to determine that the flower Bl extract in 60 mg/ml presents a higher percentage of sequestration of H2O2 with 47.25%; followed by the concentration of 20 mg/ml with 46.36%. In relation to the extract obtained from the stem of Bl, the concentration of 20 mg/ml was enough to be able to sequester H2O2 by 42.08%; followed by the 40 mg/ml concentration with 19.23%.
The leaves of Bl extract with the greatest effect on the retention of H2O2 was that of 20 mg/ml concentration. While the root extract did not show any positive effect for this analysis, as shown in table 5.
Table 5: Antioxidant capacity test of Baccharislatifolia extracts
| Extract | Concentration (mg/ml) | % of kidnapped peroxide |
| Flower | 20 | 46.36 |
| 40 | 41.04 | |
| 60 | 47.25 | |
| Stem | 20 | 42.08 |
| 40 | 19.23 | |
| 60 | 18.72 | |
| Leaves | 20 | 5.62 |
| 40 | 3.92 | |
| 60 | 0.84 | |
| Root | 20 | 0.00 |
| 40 | 0.00 | |
| 60 | 0.00 |
The extracts of medicinal herbs showed inhibitory activity, as determined by a work developed by Yoon and Choi [24], where the extracts of Bogolji and Gosam showed antibacterial capacity with zone diameter>10 mm; also, Eruteya and Badón [25], obtained antilisteria activity of ethanol extracts of Moringa oleifera, with zone of inhibition>11 mm from extract concentrations of 200 mg/ml. Similar results were obtained by Ruilova et al. [18], obtained antilisteria effect of ethanolic extracts of Physalis peruviana fruits, but with zone sizes<7 mm. Odedina et al. [26], used Rhodomyrtustomentosa ethanolic leaf extract as biocontrol against Listeria monocytogenes. Also, in the work carried out by Carrizo et al. [27], reported that the essential oil of B. salicifolia inhibits the growth of Listeria monocytogenes CLIP 74904, but was inactive against the Gram-negative organisms analyzed. It should also be noted that there are no studies on the antilisterial activity of Baccharislatifolia, which shows that our research group is the first to work with extracts of this plant against Listeriaspp isolates.
In a study developed by Shan et al. [28], reported that the extracts of 26 medicinal herbs positively inhibited the development of Salmonella anatum (mean = 7.2 mm, 4.7-19.2 mm). On the other hand, the acid environment improved the antibacterial activity of the extract of Filipendulaulmaria when tested against S. enteritidis PT4, whose aqueous methanol extract contains a variety of phenolic compounds [29].
In a study conducted by N'guessan et al. [30], the aqueous extracts of Thonningiasanguinea showed an antimicrobial effect for all Salmonella strains of multiple drug resistance (S. typhi, S. typhimurium and S. hadar). In another study conducted in South Korea, by Lee et al. [31], the aqueous and methanolic extracts of Schizandraefructus showed antibacterial activity against the three Salmonella serotypes (S. typhi ATCC 19943, S. paratyphi A and S. gallinarum ATCC 9184). In addition, the root of Euphorbia balsamifera had shown high activity against S. typhimurium in comparison with the extracts of leaves and stems [32]. As well, in the study developed by our research group, the inhibitory effect of extracts of Physalis peruviana L against isolates of Salmonella spp. with inhibition zones between 8 and 10 mm [33].
In the research developed by BachirRaho and Benali [34] shows that the essential oil of Eucalyptus globulus is effective to inhibit the development of Escherichia coli with zone sizes ranging from 8 to 26 mm in diameter. According to Argote-Vera et al. [35], mentions that the essential oils of eucalyptus and mandarin inhibit in a 13.2 μl/ml and lemon 14.6 μl/ml, demonstrating that the essential oils of eucalyptus, lemon peel and mandarin have the inhibitory capacity to the bacteria Escherichia coli (ATCC 25922) and Staphylococcus aureus (ATCC 25923). Also, in the research developed by Bastos [36], oregano oil was more effective against Escherichia coli with 0.35% CBM (minimum bactericidal concentration), with an inhibition zone of 29.5±3.4 mm.
Similarly, Sequeda et al. [16], studied extracts of Baccharislatifolia obtained by percolation, maceration and soxhlet, but did not observe an inhibitory effect on E. coli, although it did act positively against other pathogens.
In general, the chemical compound of the plant extract has revealed the presence of several components, most of which have important antimicrobial properties [37]. The properties present in Baccharis species are constituted mainly in flavonoids, monoterpenes, diterpenes, triterpenes, tannins, quinones, saponins, as well as some phenolic compounds, where flavonoids are distinguished by confer protection/resistance against attack of microorganisms [38, 37, 16]. Coumarins and essential oils have also been obtained of Baccharis species [39].
In addition, there are studies that show that monoterpenes are the components that also act in the inhibition of microorganisms, [40]. Other researchers state that the phenolic compound in the plant contributes significantly to its antimicrobial and antioxidant properties [41]. This study is the first to analyze the antibacterial effect of extracts of Baccharislatifolia (root, stem, leaves and flowers) on isolated Listeria, Salmonella and E. coli.
In a study developed by Guerra [42], they analyzed the antioxidant activity of the essential oil of the Baccharislatifolia-β carotene test, with concentrations of 26 and 64 mg/ml of Bl oil obtained values of 40.56% and 46.20% respectively. In our study, the extracts of flowers were the only ones that approximate these results. Cucurbita pepo extracts inhibited the peroxidation of linoleic acid at 5.1-30.4% after incubation for 96 h [43].
In another study conducted by Hossain et al. [44], obtained a value of 48.6% with lipophilic extracts of mixed Cucurbita, in Peru a study by Doroteo et al. [45], determined the antioxidant effect of cat's claw (Uncariatomentosa) with an effect of 47%.
So also, Rodriguez et al. [46], determined the effect of an extract of Boccaniafrutencens L with a capture value of 40% with an extract concentration of 25 mg/l.
Extracts of leaves and flowers of Baccharislatifolia acted better against Listeria and Salmonella isolates, whereas in E. coli isolates; Flower and stem extracts were the best. In short, these extracts proved to be equal to or better than the antibiotics for clinical use, thus considering the extracts of Bl as an alternative natural product to inhibit the development of pathogens.
The authors express their gratitude to the Departamento de Investigación of the Universidad Estatal de Bolívar for allowing the experiments in their facilities, as well as to the debt Exchange program Ecuador–Spain, for the support received for carrying out the present work.
Nil
All the authors have contributed equally.
Declare none
Suarez AY, Vera V. Uso y abuso del ciprofloxacino. Medisan 2011;15:384-92.
Flores JM, Ochoa Zaragoza M, Lopez L, Trejo E, Morelos A. Drug interactions related to the administration of beta-lactam antibiotics. Revista ADM 2016;73:227-34.
Olaimat A, Al-Holy MA, Shahbaz H, Al-Nabulsi H, Abu Ghoush MH, Osaili T, et al. Emergence of antibiotic resistance in listeria monocytogenes isolated from food products: a comprehensive review. Compr Rev Food Sci Food Saf 2018;17:1277-92.
Tadesse G, Tessema T, Beyene G, Aseffa A. Molecular epidemiology of fluoroquinolone-resistant Salmonella in Africa: a systematic review and meta-analysis. PLoS One 2018;13:e0192575.
Shakti R, Rabindra N. Prevalence of fluoroquinolone resistance in Escherichia coli in an Indian teaching hospital and adjoining communities. J Taibah University Med Sci 2015;10:504-8.
Alos J. Resistencia bacteriana a los antibióticos: una crisis global. Enferm Infecc Microbiol Clin 2015;33:692-9.
Gadea R, Glibota NP, Perez R, Galvez A, Orteg AE, Fernandez M, et al. Effects of exposure to quaternary-ammonium-based biocides on antimicrobial susceptibility and tolerance to physical stresses in bacteria from organic foods. Food Microbiol 2017;63:58-71.
Mostafa AA, Al-Askar A, Almaary KS, Dawoud TM, Sholkamy EN, Bakri MM. Antimicrobial activity of some plant extracts against bacterial strains causing food poisoning diseases. Saudi J Biol Sci 2018;25:361–6.
Elisha IL, Botha FS, McGaw LJ, Eloff JN. The antibacterial activity of extracts of nine plant species with good activity against Escherichia coli against five other bacteria and cytotoxicity of extracts. BMC Complementary Alternative Medicine 2017;17: 133.
Devi W, Singh SB, Singh CB. Antioxidant and anti-dermatophytic properties leaf and stem bark of Xylosmalongi foliumclos. BMC Complement Altern Med 2013;13:155.
Ahmad R. Free radicals, antioxidants and diseases, Chapter 1. Basics of Free Radicals and Antioxidants. Intech Open 2018;1-5. http://dx.doi.org/10.5772/intechopen.76689.
Mateos R, Bravo L. Chromatographic and electrophoretic methods for the analysis of biomarkers of oxidative damage to a macromolecule (DNA, lipids and proteins). J Separation Sci 2007;30:175-91.
Atmani D, Ruiz Larrea MB, Ruiz Sanz JI, Lizcano LJ, Bakkali F, Atmani D. Antioxidant potential, cytotoxic activity and phenolic content of Clematis flammula leaf extracts. J Med Plants Res 2011;5:589.
Valarezo E, Rosillo M, Cartuche L, Malagon O, Meneses M, Morocho V. Chemical composition, antifungal and antibacterial activity of the essential oil from Baccharislatifolia (Ruiz and Pav.) Pers. (Asteraceae) from Loja, Ecuador. J Essential Oil Res 2013;25:233-8.
Salcedo Ortiz L, Almanza Vega G. Uso de Baccharis latifolia (Chilca) en La Paz, Bolivia. Biofarbo 2011;19:59-63.
Sequeda L, Ramos V, Monroy EC, Matulevich J, Tellez AN, Luengas PE. Actividad microbiana de Baccharis latifolia (Ruiz and Pavón) Pers, (Asteraceae) sobre microorganismos patogenos y cariogénicos. V Congreso Iberoamericano de Productos Naturales XIII Congreso Colombiano de Fitoquimica VIII Congreso Colombiano de Cromatografía, Sociedad Colombiana de Ciencias Químicas 2016;BA-24. Doi:10.13140/RG.2.1.3721.3047.
Shokeen P, Bala M, Tandon V. Evaluation of the activity of 16 medicinal plants against neisseriagonorrhoeae. Int J Antimicrobial Agents 2009;33:86-91.
Ruilova Cueva M, Tigre Leon RA, Lopez M, Yanchaliquin A, Bayas Morejon F, Sanaguano H. Antibacterial effects of uvilla (Physalis peruviana L.) stractsagaints Listeria spp. Isolated from meat in Ecuador. Int J Curr Microbiol Appl Sci 2017;6:1146-53.
Ponce A, Roura S, Del Valle C, Moreira M. Antimicrobial and antioxidant activities of edible coatings enriched with natural plant extracts: in vitro and in vivo studies. Postharvest Biol Technol 2008;49:294-300.
Ruch R, Cheng SJ, Klaunig JE. Prevention of cytotoxicity and inhibition of intracelular communication by antioxidant catechins isolated from Chinese green tea. Carcinogenesis 1989;10:1003-8.
Perez Jimenez J. Metodologia para la evaluacion de ingredientes funcionales antioxidantes efecto de fibra antioxidante de uva en status antioxidante y parámetros de riesgo cardiovascular en humanos. Tesis Doctoral Universidad Autonoma de Madrid; 2007. p. 272.
CLSI. Manual de actualización en resistencia bacteriana y normas CLSI M100-S20. Grebo. Capitulo 2012;3:6-8.
Preston S, Drusano G. Penicillins infectious disease antimicrobial agentes. Antimicrobe 2008;32:373
Yoon Y, Choi KH. Antimicrobial activities of therapeutic herbal plants against Listeria monocytogenes and the herbal plant cytotoxicity on caco-2 cell. Lett Appl Microbiol 2013;55:47–55.
Eruteya O, Badon B. Antilisterial activity of ethanolic and aqueous extracts of the leaves and seeds of Moringa oleifera. Asia J Appl Microbiol 2014;1:60-5.
Odedina GF, Vongkamjan K, Voravuthikunchai SP. Use of Rhodomyrtustomentosa ethanolic leaf extract for the bio-control of Listeria monocytogenes post-cooking contamination in cooked chicken meat. J Food Sci Technol 2016:53:4234–43.
Carrizo R, Ponzi M, Ardanaz C, Tonn CE, Donadel O. Chemical composition of essential oil of Baccharissalicifolia (RUIZ and PAVON) pers and antibacterial activity. J Chilean Chem Soc 2009;54:475-6.
Shan B, Cai Y, Brooks J, Corke H. The in vitro antibacterial activity of dietary spice and medicinal herb extracts. Int J Food Microbiol 2007;117:112-9.
Boziaris IS, Proestos C, Kapsokefalou M, Komaitis M. Antimicrobial effect of Filipendulaulmaria plant extract against selected foodborne pathogenic and spoilage bacteria in laboratory media, fish flesh and fish roe product. Food Technol Biotechnol 2011;49:263–70.
N'guessan JD, Coulibaly A, Ramanou AA, Okou OC, Djaman AJ, Guede Guina F. Antibacterial activity of thonningiasanguinea against some multi-drug resistant strains of Salmonella enteric. Afr Health Sci 2007;7:155–8.
Lee MH, Kwon HA, Kwon DY, Park H, Sohn DH, Kim YC, et al. Antibacterial activity of medicinal herb extracts against Salmonella. Int J Food Microbiol 2006;111:270–5.
Kamba AS, Hassan LG. Phytochemical screening and antimicrobial activities of Euphorbia balasamifera leaves stems and root against some pathogenic microorganisms. Afr J Pharm Sci Pharm 2010;1:57-64.
Bayas Morejon F, Tigre Leon A, Ruilova M, Ramon R. Actividad antibacteriana de extractos de Physalis peruviana L. contra cepas de Salmonellaspp. aisladas de carnes. XXI Congreso Nacional de Microbiología de los Alimentos Sesion 3A Productos Carnicos; 2018. p. 172-3.
Bachir Raho, Benali. Antibacterial activity of the essential oils from the leaves of Eucalyptus globules against Escherichia coli and Staphylococus aureus. Asian Pacific J Trop Biomed 2012;2:739-42.
Argote Vega F, Suarez Montenegro Z, Tobar Delgado M, Perez Alvarez J, Hurtado Benavides A, Delgado Ospina J. Evaluación de la capacidad inhibitoria de aceites esenciales en Staphylococcusaureus y Escherichia coli. Biotecnología en el Sector Agropecuario y Agroindustrial. Edición Especial No 2 · julio–diciembre; 2017. p. 52-60.
Bastos Oyarzabal M, Dame Schuch L, de Souza L, Almeida D, Alves Rodriguez M, Braga de Mello J. Actividad antimicrobiana de aceite esencial de Origanumvulgare L. ante bacterias aisladas en leche de bovino. Rev Cubana Plant Med 2011;16:260-6.
Prada J, Orduz Diaz L, Coy Barrera E. Baccharislatifolia: a lowly-valued asteraceous plant with chemical and medicinal potential in neotropics. Revista Facultad de Ciencias Básicas, Universidad Militar Nueva Granada 2016;12:92-105.
Martinez S, Terraza E, Alvarez T, Manani O, Vila J, Mollinedo P. Actividad antifungica in vitro de extractos polares de plantas del genero baccharis sobre fitopatogenos. Rev Boliv Quim 2010;27:13-8.
Abad M, Bermejo P. Baccharis (Compositae): a review update. ARKIVOC 2007;7:76-96.
Ramadan M, El-Ghorab A, Ghanem K. Volatile compounds, antioxidants, and anticancer activities of cape gooseberry fruit (Physalis peruviana L.): an in vitro study. J Arab Soc Med Res 2015;10:56-64.
Hara Kudo Y, Kobayashi A, Sugita Konishi Y, Kondo K. Antibacterial activity of plants used in cooking for aroma and taste. J Food Protection 2004;67:2820–4.
Guerra P. Evaluación de la actividad antioxidante bioautografica de dos variedades de aceites esenciales andinos Clinopodiumnubigenum (Kunt) Kuntze y Baccharis latifolia (Ruiz andPav.) Pers. trabajo de titulacion previo a la obtención del titulo de: Ingeniero en biotecnologia de los recursos naturales, Universidad Politecnica Salesiana 2016. p. 80.
Baljeet SY, Roshanlal Y, Ritika BY. Effect of cooking methods and extraction solvents on the antioxidant activity of summer squash (Cucurbita pepo) vegetable extracts. Int Food Res J 2016;23:1531-40.
Hossain SJ, Sultana S, Abu Taleb M, Basar M, Sarower M, Hossain SK. Antioxidant activity of ethanol and lipophilic extracts of common fruity vegetables in Bangladesh. Int J Food Properties 2014;17:2089-99.
Doroteo VH, Diaz C, Terry C, Rojas R. Compuestos fenolicos y actividad antioxidante in vitro de 6 plantas peruanas. Rev Soc Quim Peru 2013;79:13-20.
Rodriguez O, Andrade W, Diaz F. Antioxidant activity of extracts from leaves of Bocconiafrutescens L. (Papaveraceae). J Technol 2015;14:21-36.